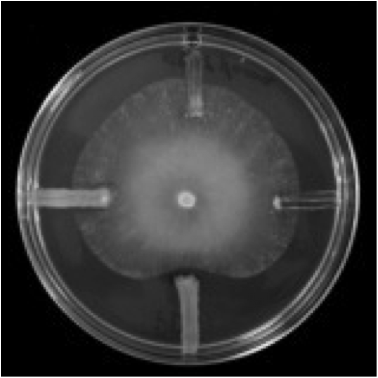
Ensayo de antibiosis. Como pequeñas rayas a las 12, 3, 6 y 9 de la placa (si esta fuera un reloj)  sembraron 4 especies de bacterias y en el centro sembraron un hongo patógeno de plantas. La bacteria sembrada a las 6 inhibe el crecimiento de este hongo, Pythium ultimum.

Publicado en Revista Persea.
Léelo completo en su sitio: https://www.revistapersea.com/ambiente-1/jaque-mate-a-los-glaciares-tropicales
01/2/2018
Venezuela será el primer país del mundo cuyos glaciares desaparezcan.

Ilustración de Ada Peña
Caribay solía pasear cándidamente por las montañas de los andes venezolanos. Ella era la hija de la Luna y del Sol. Controlaba el canto de los pájaros, la floración de las plantas y tenía todo el poder de la naturaleza. Sin embargo, sentía que le faltaba algo más: quería el plumaje de cinco águilas blancas que deambulaban aquellos parajes; el más bello que había visto jamás.
Caribay se dedicó a perseguir a esas aves, quienes volaban de cumbre en cumbre sin dejarse atrapar. Su frustración y sus llantos compadecieron a su madre, la Luna, y esta mandó a las águilas a que se posasen cada una en los cinco picos más altos de aquellas montañas. Finalmente, Caribay podría atraparlas y hacerse con sus plumajes. Pero ninguna de las dos contaba con que una súbita ventisca congelaría a las aves, haciendo que quedaran ahí en forma de hielo y nieve para el resto de la eternidad.
Según la mitología andina venezolana, fue más o menos así el origen de las nieves perpetuas sobre los picos Humboldt y Bonpland (4940 y 4883 msnm respectivamente), La Concha (4922 msnm), El León (4740 msnm), El Toro (4727 msnm) y Bolívar (4978 msnm), del parque nacional Sierra Nevada. En el transcurso de miles de años, esas nieves se fueron acumulando, compactando y recristalizando hasta originar gruesas masas de hielo: glaciares.

Panorámica de los cinco picos con nieves «perpetuas» en los Andes venezolanos
¿Glaciares en el trópico?
Parece paradójico, pero sí. Los glaciares tropicales son particularmente especiales, únicos y sensibles. Se ubican en las regiones más cálidas del planeta y en latitudes donde las estaciones no existen, por lo que no acumulan hielo. Son relativamente pequeños y se encuentran en las cotas más altas de montañas aisladas. Por esta razón, son especialmente sensibles a los cambios climáticos y son considerados como excelentes indicadores del calentamiento global. Una triste excelencia, si se quiere.
Los glaciares tienen una enorme importancia ambiental y económica. La disponibilidad de agua fresca que emana de ellos es usada para riego y para uso doméstico. También para la recreación de montaña, el turismo, los animales y las plantas. Pueblos y ecosistemas enteros dependen del deshielo glaciar natural.
Ciudades como La Paz o Quito, por poner apenas dos ejemplos, dependen casi exclusivamente del deshielo de los glaciares para suplir de agua potable a su población. En otros países, como Perú y Colombia, numerosas poblaciones rurales y agrícolas también dependen de estas fuentes de agua fresca.
Además de esto, ellos esconden otro secreto que fue el que motivó la escritura de este artículo. Ya verán.
Las nieves no resultaron tan perpetuas
Con lo que no contaba Caribay, era que los humanos íbamos a arruinarlo todo. Que nuestro crecimiento y desarrollo traería como consecuencia que nuestro planeta se calentara. Que pondríamos en jaque a los glaciares del mundo y en jaque mate a los glaciares tropicales. Ya cuatro de sus águilas han escapado, la quinta lo hará dentro de poco tiempo.
Ya han desaparecido cuatro glaciares venezolanos. Al quinto y último glaciar le quedan, aproximadamente, 10 años de vida. El menguante glaciar La Corona, en el pico Humboldt, es hoy diez veces más pequeño que en 1991. El derretimiento de esta masa de hielo es la etapa final de un proceso que ha durado 20000 años, cuando el glacial originalmente cubría 600 km2 en el periodo de glaciación más reciente. El cambio climático acelera su fin. Esta masa de hielo desaparecerá por completo y Venezuela se convertirá en el primer país del mundo en perder todos sus glaciares.

Pico Humboldt y el glaciar La Corona, el último que queda en el país

Proyección de las áreas glaciares de Venezuela. La pérdida es inevitable.

Pico Bolívar, el más alto de Venezuela, en 1950 y 2011.
Un tesoro microbiológico (también) se pierde
Como les decía, los glaciares esconden un secreto: microorganismos. No se sabe muy bien cómo llegaron ahí. Tal vez junto con el polvo del aire, o de la lluvia, o de la atmósfera, o todo eso combinado. Lo cierto es que en ese hielo están atrapadas criaturas diminutas que tienen un inmenso interés biotecnológico. Los glaciares son una suerte de bóveda natural que resguarda una diversidad microbiana única.
Estos gélidos microorganismos son capaces de producir enzimas que funcionan a bajas temperaturas. Esto supone una gran ventaja para aplicaciones biotecnológicas industriales, donde la optimización de los procesos es cada vez más demandante. Además, estos bichitos podrían ser también útiles para otras aplicaciones, por ejemplo en la agricultura.
Teniendo esto en mente, investigadores de la Universidad de Los Andes (Mérida, Venezuela) se propusieron aislar bacterias de los hielos tropicales venezolanos. Escalaron hasta esas cumbres, tomaron muestras del hielo glacial en el pico Humboldt, en el laboratorio las sembraron sobre placas para crecimiento bacteriano y Voilà! Revivieron los micro habitantes congelados del glaciar merideño.
Biofertilizantes como alternativa a agroinsumos sintéticos
Una de las medidas para no contribuir más con la emisión de gases invernaderos (que ocasionan el calentamiento global) es hacer de la agricultura una práctica más amigable al ambiente. Para lograr esto, una alternativa es disminuir el uso de fertilizantes sintéticos y aumentar el uso de microbios beneficiosos como complemento. No es una idea nueva, pero recibe cada vez más atención de científicos, agricultores y consumidores. El mercado de los fertilizantes biológicos (biofertilizantes) tiene un crecimiento sostenido y no es difícil imaginar por qué.
Los microbios usados como biofertilizantes son capaces de producir hormonas vegetales que ayudan a la planta a crecer, o les proporcionan nutrientes, u ofrecen protección frente a otros patógenos. Así como nuestra microbiota intestinal está estrechamente ligado a nuestra salud, la microbiota de las plantas es también responsable del sano desarrollo de nuestros cultivos.
Sin embargo, el uso de biofertilizantes ha estado restringido a climas cálidos o templados, principalmente porque los microbios que se usan viven en esas condiciones. Pero ahora las bacterias aisladas del glaciar del pico Humboldt podrían ayudar a los productores andinos a mejorar su agricultura.
Biofertilizantes glaciares para la agricultura en climas fríos
Los científicos merideños, encabezados por Wilvis Balcázar, determinaron que un grupo de esas bacterias poseen actividades que promueven el crecimiento de las plantas. Ellos demostraron que los microorganismos glaciares son capaces de:
-
Excretar auxinas vegetales. Esta sustancia es la hormona de crecimiento de las plantas. Al producirla, las bacterias ayudan a que la planta crezca sana, fuerte y rápido.
-
Solubilizar el fósforo de las rocas. Algunas bacterias son capaces de «sudar» ácidos orgánicos que solubilizan las rocas. Los minerales que se desprenden de esta solubilización (véanlo como una predigestión), como el fósforo, son nutrientes esenciales para el desarrollo las plantas.
-
Producir antibióticos. Los microorganismos, como cualquier ser vivo, tienen medios de defensa. Ellos deben competir por recursos (comida y «vivienda») y deben protegerse del ataque de enemigos. Su mejor arma son los antibióticos. Estas bacterias producen sustancias que inhiben o impiden el crecimiento de otros microorganismos que enferman a los cultivos.
Y todo esto lo hacen cuando las cultivan entre 0 y 15 °C, ¡Esto resulta asombroso!

Ensayo de solubilización de fósforo. Sembraron una gota de 9 cultivos bacterianos glaciares distintos en una placa que contenía fosfatos. Luego de unos días, un halo translúcido se formó alrededor de las bacterias que fueron capaces de solubilizar minerales.
Ensayo de antibiosis. Como pequeñas rayas a las 12, 3, 6 y 9 de la placa (si esta fuera un reloj) sembraron 4 especies de bacterias y en el centro sembraron un hongo patógeno de plantas. La bacteria sembrada a las 6 inhibe el crecimiento de este hongo, Pythium ultimum.
Si bien es cierto que estos análisis son exploratorios y que la actividad de estas bacterias para promover el crecimiento de las plantas debe ser aún demostrado en ensayos de campo, el potencial que tienen estos microorganismos para mejorar la agricultura en climas fríos es tremendo. Me emociona pensar en que los campesinos andinos cuenten con biofertilizantes glaciares para producir nuestros alimentos.
Sin embargo, si consideramos la desaparición inminente de estas masa de hielo, la preservación y el estudio de ese tesoro microbiológico es urgente. Solamente el trabajo de los científicos merideños permitirá asegurar que esto sea una posibilidad en el futuro. Ellos serán los únicos capaces de consolar la tristeza de Caribay por perder a las cinco águilas blancas.
Para saber más:
- Balcázar, W., et al. (2015). Bioprospecting glacial ice for plant growth promoting bacteria. Microbiological Research, 117, 1-7.
- Braun, C and Bezada, M. (2013). The history and disappearance of glaciers in Venezuela. Journal of Latin American Geography. 12(2), 85-124.
- The death of Venezuela’s Humboldt glacier. The Economist, October 5, 2017.
- Evengaard, A. Venezuela is Losing its Last Glacier. GlacierHub, November 9, 2017.
- Infante, D. La agricultura del conocimiento. Revista Persea, Septiembre 21, 2017
